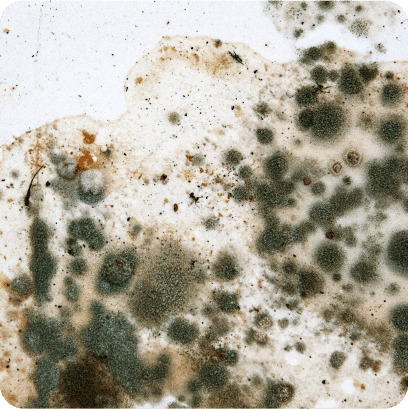

Allergy - Dust Panel, ImmunoCAP









The Allergy - Dust Panel, ImmunoCAP is a specialized allergy test that evaluates your Total IgE (antibodies produced by the immune system in response to allergens) as well as specific IgE against dust inhalant allergens using the ImmunoCAP technique. Based on the results the source of allergy/allergies is determined and the course of treatment is decided accordingly.













Understanding Allergy - Dust Panel, ImmunoCAP
Dust allergy occurs when your immune system reacts to specific particles that commonly live in household dust. The immune system mistakenly recognizes these dust particles as harmful (allergens) and produces an inappropriate response by producing antibodies (specific proteins) called Immunoglobulin E (IgE).
The Allergy - Dust Panel, ImmunoCAP is a comprehensive allergy panel that includes the Total IgE test, used to measure the total IgE levels in the blood. In addition, this test also detects the presence of specific IgE antibodies to a wide range of dust allergens, including house dust mites such as D Farinae and D Pteronsysinus, German cockroach and house dust (Greer Labs).
Your doctor may suggest the Allergy - Dust Panel, ImmunoCAP if you exhibit symptoms associated with inhalant allergy such as nasal congestion, sneezing, itchy/watery eyes, coughing, wheezing, skin rashes, hives, etc. Doctors may also perform this test if there are no specific symptoms and cause of the allergy is not clear. Allergen detection through this panel will help your doctor guide appropriate management and treatment decisions and prevent severe complications.
Generally, no special preparation is required for the Allergy - Dust Panel, ImmunoCAP. However, inform your doctor about any medications (such as antihistamines) you are taking, as they might influence your test results.
A positive test result signifies sensitivity to one or more common dust allergens, warranting further investigation through more specific allergy testing. Conversely, a negative result indicates no sensitization to the tested allergens, though it does not eliminate the possibility of allergies to other substances not covered in this panel.
Lab test results can vary depending on the specific test kit used, as different methods and the quality of allergens used can affect the quantification of IgE. Therefore, these results are intended to be interpreted in conjunction with clinical symptoms.
What does Allergy - Dust Panel, ImmunoCAP measure?
Contains 5 testsThe Allergy - Dust Panel, ImmunoCAP measures total and specific immunoglobulin E (IgE) antibodies in the blood associated with allergic reactions to dust allergens. This comprehensive panel includes house dust mites such as D Farinae and D Pteronsysinus, German Cockroach and House Dust (Greer Labs). This panel utilized the ImmunoCAP assay, a highly accurate and sensitive procedure that provides quantitative measurement of IgE antibodies and helps diagnose dust allergies and assess their severity.
The D Farinae test measures the presence and levels of specific IgE antibodies produced by the immune system in response to allergens from Dermatophagoides farinae mites (a common house dust mite). The test helps evaluate the body's immune response to dust mites, which are often found in home environments. Elevated IgE levels in response to these mites indicate an allergic sensitivity, enabling doctors to diagnose and manage allergic reactions more accurately.
The test is highly precise and reliable method that quantifies IgE antibodies, providing valuable insights into the severity of the house dust allergic response and guiding further diagnostic and treatment decisions.
Know more about D Farinae
The D Pteronsysinus test measures the presence and levels of specific IgE antibodies produced by the immune system in response to allergens from Dermatophagoides Pternonyssinus mites (a common house dust mite). This test helps evaluate the body's immune response to dust mites, which are often found in home environments. Elevated IgE levels in response to these mites indicate an allergic sensitivity, enabling doctors to diagnose and manage allergic reactions more accurately.
The test is a highly precise and reliable method that measures IgE antibodies, providing valuable insights into the severity of the D Pteronsysinus allergic response and guiding further diagnostic and treatment decisions.
Know more about D Pteronsysinus
The Cockroach test measures the presence and levels of specific IgE antibodies produced by the immune system in response to allergens found in cockroach saliva, feces, and other body parts. These allergens can spread through the air, much like dust mites, and worsen allergy symptoms. Elevated IgE levels in response to these mites indicate an allergic sensitivity, enabling doctors to diagnose and manage allergic reactions more accurately. This test is a highly precise and reliable method that quantifies IgE antibodies, providing valuable insights into the severity of the cockroaches allergic response and guiding further diagnostic and treatment decisions.
Know more about Cockroach
The Total IgE (Immunoglobulin E) test is used to quantify the total level of IgE antibodies in your blood. Immunoglobulins are antibodies (proteins) secreted by plasma cells (immune cells) when the body identifies a dangerous foreign substance like bacteria, viruses, or allergens. There are five basic forms of immunoglobulins: IgA, IgG, IgM, IgD, and IgE. Of these, IgE plays a primary role in allergic reactions to allergens such as pollen, dust, pet dander, mold, latex, some foods (such as eggs, peanuts, or strawberries), or insect stings.
Unlike other antibodies, IgE is primarily associated with immune responses to allergenic substances, such as plant pollen, latex, pet dander, mold, eggs, peanuts, bee venom, and strawberries. Typically, IgE is present in tiny amounts in the blood. When the immune system encounters an allergen, it triggers the production of IgE antibodies. The Total IgE test measures the concentration of these IgE antibodies in the blood, providing insights into the presence and severity of allergies.
Know more about Total IgE
The House Dust (Greer Labs) test measures the presence and levels of specific IgE antibodies produced by the immune system in response to dust particles from Greer Labs. It evaluates the body's immune response to allergens, commonly found in house dust, such as fabric fibers, bacteria, fungi, and human skin cells. Elevated IgE levels in response to Greer Labs dust indicate an allergic sensitivity, helping doctors pinpoint the exact allergen triggering symptoms and tailor appropriate treatment strategies.
This test is a highly precise and reliable method that quantifies IgE antibodies, providing valuable insights into the severity of the house dust allergic response and guiding further diagnostic and treatment decisions.
Know more about House Dust (Greer Labs)





FAQs related to Allergy - Dust Panel, ImmunoCAP
- Aggarwal P, Senthilkumaran S. Dust Mite Allergy. [Updated 2023 Aug 8]. In: StatPearls [Internet]. Treasure Island (FL): StatPearls Publishing; 2024 Jan-. Available from:
- Allergens [Internet]. NIH; 07 Sep. 2022. [Accessed 16 Aug. 2024]. Available from:
- InformedHealth.org [Internet]. Cologne, Germany: Institute for Quality and Efficiency in Health Care (IQWiG); 2006-. Allergies: Overview. [Updated 2020 Apr 23]. Available from:
- McLendon K, Sternard BT. Anaphylaxis. [Updated 2023 Jan 26]. In: StatPearls [Internet]. Treasure Island (FL): StatPearls Publishing; 2023 Jan-. Available from:
- Portnoy JM. Appropriate allergy testing and interpretation. Mo Med. 2011 Sep-Oct;108(5):339-43. PMID: 22073491; PMCID: PMC6188374. [Accessed 16 Aug. 2024]. Available from:
- Murphy PB, Atwater AR, Mueller M. Allergic Contact Dermatitis. [Updated 2023 Jul 13]. In: StatPearls [Internet]. Treasure Island (FL): StatPearls Publishing; 2023 Jan-. Available from:
- Birch K, Pearson-Shaver AL. Allergy Testing. [Updated 2023 Jul 24]. In: StatPearls [Internet]. Treasure Island (FL): StatPearls Publishing; 2023 Jan-. Available from:
- Sinclair D, Peters SA. The predictive value of total serum IgE for a positive allergen-specific IgE result. J Clin Pathol. 2004 Sep;57(9):956-9. [Accessed 16 Aug. 2024]. Available from:
Other tests
- PT INR (Prothrombin Time with INR)
- HIV 1 and 2 Antibody, Rapid Screening Test
- Viral Marker Screening (HIV, HBsAg, Anti-HCV)
- Total IgE
- Rheumatoid Factor - Quantitative
- STD Panel (Sexually Transmitted Diseases Panel)
- HIV Combo (Antigen And Antibody) Test
- Anti-CCP Antibody
- Lipid Profile, Non Fasting
- Anti-Nuclear Antibody (ANA) by IFA - End Point Titer
- CBC (Complete Blood Count)
- FBS (Fasting Blood Sugar)
- Thyroid Profile Total (T3, T4 & TSH)
- HbA1c (Glycosylated Hemoglobin)
- PPBS (Postprandial Blood Sugar)
- Lipid Profile
- Vitamin D (25-Hydroxy)
- Urine R/M (Urine Routine & Microscopy)
- Coronavirus Covid -19 test- RT PCR
- LFT (Liver Function Test)
- KFT (Kidney Function Test)
- TSH (Thyroid Stimulating Hormone) Ultrasensitive
- ESR (Erythrocyte Sedimentation Rate)
- Uric Acid, Serum
- Vitamin B12
- CRP (C-Reactive Protein), Quantitative
- Urine C/S (Urine Culture and Sensitivity)
- Serum Electrolytes
- Serum Calcium
- Serum Creatinine
- Diabetes Screening (HbA1C & Fasting Sugar)
- KFT with Electrolytes (Kidney Function Test with Electrolytes)
- Cholesterol - Total
- Hb (Hemoglobin)
- Complete Hemogram (CBC & ESR)